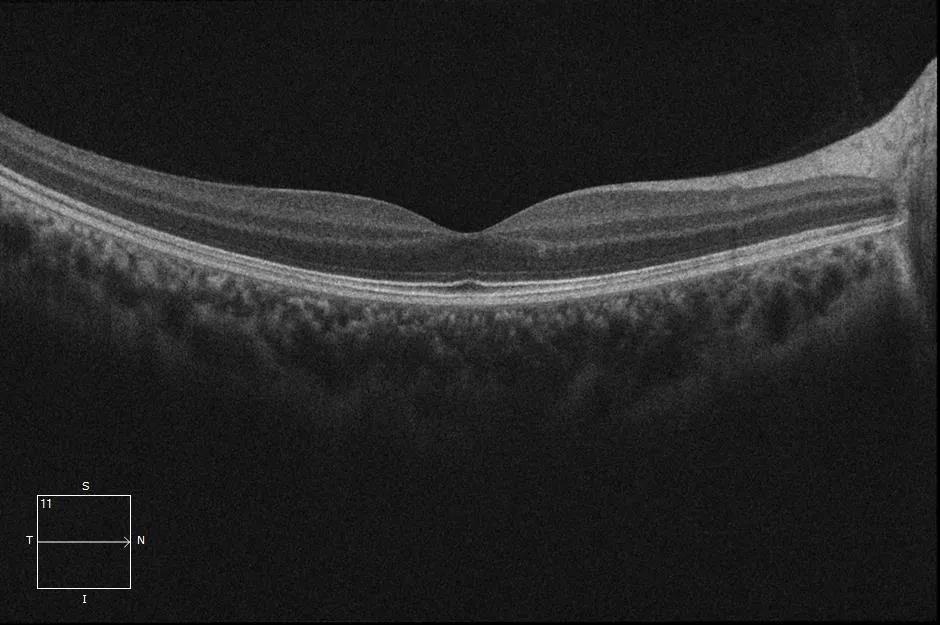
\

男子视物扭曲变形 武汉普瑞眼科紧急修补助其重获光明
5月14日上午,武汉普瑞眼科医院眼底病专科许泽骏院长顺利为72岁的鲍先生实施了眼睛“修补”手术,并为其保住了丢失的视力。
视力下降看东西扭曲误以为是白内障
今年72岁的鲍先生是一名退休职员,近半年来他感觉到自己的眼睛看东西越来越模糊,平日里热爱运动的他身体也格外硬朗,便没有把此事放在心上。前不久,他陪孙子玩弹珠跳棋游戏被吐槽作弊,发现是自己把直线看歪了。鲍先生一边纳闷是不是得了老年人常见的白内障,一边同时交替用手捂住自己的眼睛寻找异常,这才发现左眼睛视力很差,看东西也是扭曲变形,中间还有一块黑点。于是,他立即前往家附近的武汉普瑞眼科医院。
眼睛内有“破洞”竟是黄斑裂孔惹的祸
5月13日下午,鲍先生独自一人来到武汉普瑞眼科医院挂了专家号,在医院大厅眼底病专科门诊内,鲍先生见到了眼底病专科的许泽骏院长,随后,许院长为其进行了详细的裂隙灯检查,并开具了系统的眼底检查单。
做完检查拿着报告单的鲍先生已是忧心忡忡,沮丧着头将检查结果递给了许院长,许院长看完鲍先生的眼底OCT检查结果报告轻声的告诉他:“老人家,您这个是眼底黄斑裂孔,不是什么白内障啊,需要马上做手术。”还未缓过神的鲍先生惊愕的问道:“这是什么病啊?这么严重,需要做手术吗?”许泽骏院长耐心的解释到:“这个眼底OCT检查结果图上可以清楚看到有一个404μm缺口,这个就是黄斑裂孔。您的视力很差,且看东西变形,都是他它惹的祸,这是一种常见特发性黄斑裂孔,会严重损害您的中心视力,是因为眼睛内黄斑部视网膜内界膜至感光细胞层发生的组织缺损,因而常被大众称为眼睛里面破了一个洞。”

鲍先生眼底黄斑裂孔 404um
眼底图片
40分钟细心解答换来坚定的信任
“什么?不做手术严重的还会?就算做了手术视力也不能保 证恢复视力吗?那我为什么要做手术,自己还要遭罪呢?你是不是故意吓我,让我做手术!你可不要欺负我年纪大。”鲍先生激动的大声说到。
许泽骏院长不急不慢听鲍先生说完后解答到,黄斑是眼内看东西敏感的部位,而黄斑裂孔是黄斑中心全层神经上皮缺失,一般分为继发性和特发性两种。继发性可由眼外伤、黄斑变性、长期黄斑囊样水肿、高度近视等引起,特发性黄斑裂孔病因尚不明确,但占据黄斑裂孔发病总人数的绝大多数。您的这个情况就属于常见特发性黄斑裂孔。
“特发性黄斑裂孔形成过程主要分为四期,发病初期视力会有轻度下降,数日或数月后视力还会出现进一步下降,而您的眼底OCT检查结果显示黄斑裂孔有404μm,属于III期阶段,目前建议您尽快手术,一方面是避免视力再次下降而导致的视力缺失等不可逆后果,另一方面希望能通过手术帮助恢复视力的可能。”许院长说道。

(许院长细心耐心为鲍先生解答疑惑图)
经过40分钟的来回交流和许院长的耐心讲解,鲍先生心中的疑惑被解答,并选择相信他面前这位“聪明绝顶(鲍先生原话:光头)”的眼科医生。
紧急修补“破洞”精湛技术助其重获光明
5月14日上午,在鲍先生坚定的信任下,凭借数十年的眼科手术经验,武汉普瑞眼科医院许泽骏院长在术中OCT导航显微镜下为鲍先生进行了玻璃体切除联合内界膜剥离手术,历经60分钟,手术顺利完成。当问到鲍先生感觉如何时,他表示很,没有任何不适感。
“黄斑裂孔的手术方法主要是用玻璃体切除手术,手术采用局部麻醉、术中微痛感:要先行玻璃体切除,切除黄斑孔周围的玻璃体,同时撕除裂孔周围的视网膜内界膜,封闭裂孔,术中有可能要在玻璃体腔内填充气体,通过气泡的顶压作用促进裂孔愈合。因为是在眼内进行手术,需要格外谨慎小心,更需要经验丰富的手术医生来操作。”许院长说到。
5月15日上午,许院长为鲍先生复查了术眼,并测量了术后视力,结果显示恢复良好。这让鲍先生意外的开心,原本手术前谈完话后,他只抱着保留现有视力不在下降的心态,而今天的结果却令他格外惊喜。
医患关系本就像鱼和水,谁都离不开谁,作为医生需要多方面考虑患者的需求及感受,作为患者也要体谅医生的工作艰辛,彼此相互依存,相互帮助与信任。发生在鲍先生和许院长两人身上的故事,告诉我们医患之间多一份耐心,多一份细心,便是多一份信心与信任。许泽骏院长也正是以武汉普瑞眼科医院全 面打造“三全眼专业服务机构”的理念而身体力行,坚持为广大百姓提供“全年龄段、全程视力、全视觉场景”的眼服务。

许泽骏
副主任医师
武汉普瑞眼科医院业务副院长
武汉普瑞眼科医院眼底病科主任
医学会眼科学分会会员
武汉市医学会医疗事故技术鉴定专家
2018年获湖北地区“光明中国行”光明导师称号
从事眼底疾病的诊断和20余年,擅长各类玻璃体视网膜疾病、糖尿病视网膜病变等的诊治,擅长玻璃体切割术及眼外伤的处理,在复杂视网膜脱离、玻璃体视网膜疾病、糖尿病视网膜病变、复杂眼外伤的玻璃体重建以及玻璃体手术等方面具有较深的造诣和丰富的手术经验。曾在眼科专业杂志发表论文10余篇,并在国内各大知名眼科医院进修学习。
擅长:各类眼底疾病的诊断及,尤其对复杂性视网膜脱离、玻璃体视网膜疾病、糖尿病视网膜病变等方面具有丰富的手术经验。
【免责申明】文章部分配图来自网络,如涉及版权与其他问题等,请及时与我们联系,我们将及时予以处理解决并删除。联系电话027-50108888(周先生)武汉普瑞眼科医院拥有对此声明的解释权。
【温馨提示】更多眼科问题,欢迎点击在线咨询,网上预约,享更多优惠!详询027-50108889。
专家推荐:想了解更多?问专家
手机挂号




